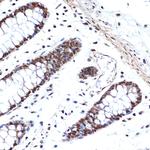
HMGB2 Antibody in Immunohistochemistry (Paraffin) (IHC (P))

Search
Invitrogen
HMGB2 Recombinant Rabbit Monoclonal Antibody (8P10V5)
{{$productOrderCtrl.translations['antibody.pdp.commerceCard.promotion.promotions']}}
{{$productOrderCtrl.translations['antibody.pdp.commerceCard.promotion.viewpromo']}}
{{$productOrderCtrl.translations['antibody.pdp.commerceCard.promotion.promocode']}}: {{promo.promoCode}} {{promo.promoTitle}} {{promo.promoDescription}}. {{$productOrderCtrl.translations['antibody.pdp.commerceCard.promotion.learnmore']}}
图: 1 / 7
HMGB2 Antibody (MA5-35771) in ICC/IF

Please note: We are reviewing Western blot images included in the antibody testing data in our catalog, including those provided by third parties. Unless expressly labeled or annotated as “raw-unedited”, Western blot images included in the antibody testing data in our catalog may have been edited, optimized or otherwise adjusted for presentation.
产品信息
MA5-35771
种属反应
宿主/亚型
Expression System
分类
类型
克隆号
抗原
偶联物
形式
浓度
规格
纯化类型
保存液
内含物
保存条件
运输条件
RRID
产品详细信息
Immunogen sequence: MGKGDPNKPR GKMSSYAFFV QTCREEHKKK HPDSSVNFAE FSKKCSERWK TMSAKEKSKF EDMAKSDKAR YDREMKNYVP PKGDKKGKKK DPNAPKRPPS
靶标信息
HMGB2 encodes a member of the non-histone chromosomal high mobility group protein family. The proteins of this family are chromatin-associated and ubiquitously distributed in the nucleus of higher eukaryotic cells. In vitro studies have demonstrated that this protein is able to efficiently bend DNA and form DNA circles. These studies suggest a role in facilitating cooperative interactions between cis-acting proteins by promoting DNA flexibility. This protein was also reported to be involved in the final ligation step in DNA end-joining processes of DNA double-strand breaks repair and V(D)J recombination.
仅用于科研。不用于诊断过程。未经明确授权不得转售。
篇参考文献 (0)
生物信息学
蛋白别名: High mobility group protein 2; High mobility group protein B2; HMG 2; HMG B2; HMG-2; HMG-B2; HMGB-2
基因别名: C80539; HMG-2; HMG2; HMGB2
UniProt ID: (Rat) P52925, (Mouse) P30681
Entrez Gene ID: (Rat) 29395, (Mouse) 97165




